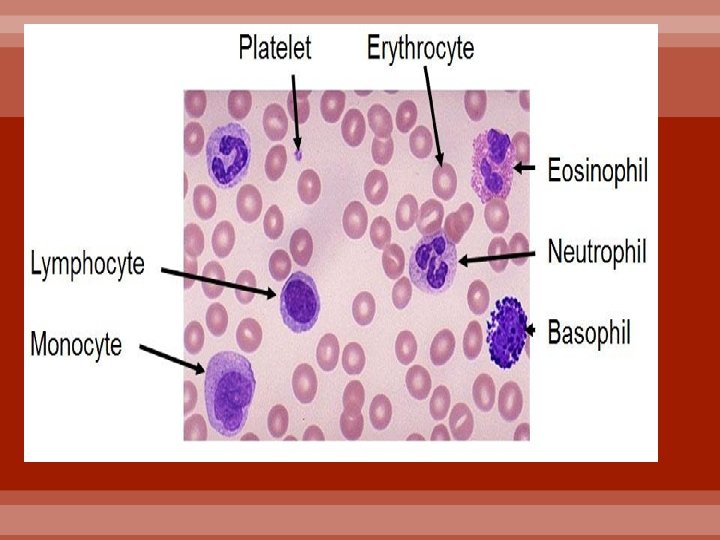

BLOOD CHAPTER 10 History of Blood Transfusion Play

BLOOD CHAPTER 10 History of Blood Transfusion Play TPT Blood Cells Video

BLOOD FACTS The average life span of a single red blood cell (RBC) is 120 days The kidneys filter over 400 gallons of blood a day You have about 5 liters of blood in your body -only fluid tissue in the body Blue Blood? Light penetrating the skin is reflected back to eye – only high E wavelengths bounce back–which are blue! Must be at least 17 yrs. old, weigh more than 110 -lbs. & be in good general health

Blood ics st i r e t c Chara • O 2 Rich = Bright Red • O 2 Poor = Color Deep Red p. H Temp. • Must remain between 7. 35 -7. 45 (acidosis vs. alkalosis) • Slightly higher than body temperature • 100. 4˚F

Blood ics st i r e t c Chara Consistency • Sticky, thick, opaque fluid that sinks in H 20 Taste Volume • Metallic • Avg. 5 L • 7% of body weight

ion t i s o p Com WBC RBC P

Blood Testing can be used to monitor and diagnose abnormalities Blood and The Cardiovascular System 6

The blood sample is spun in a centrifuge to separate the formed elements from plasma. Often, blood is collected in a capillary tube and centrifuged. Blood and The Cardiovascular System 7

ion t i s o p Com (LESS THAN 1%) BUFFY COAT SUSPENDED IN PLASMA (~55%) ARE THE FORMED ELEMENTS (~45%)

ion t i s o p Com Blood Plasma Composed of ~90% water Water Salts Nutrients and Wastes Proteins and Hormones Respiratory Gases Includes many dissolved substances

ion t i s o p Com Proteins in the plasma…. ALBUMIN Regulates osmotic pressure nourishes tissues, transports materials, maintains p. H CLOTTING PROTEINS ANTIBODIES Help to stop blood loss when a blood vessel is injured Help protect the body from antigens (harmful substances such as bacteria & viruses)

ion t i s o p Com Erythrocytes (RBC’s) Formed Elements Leukocytes (WBC’S) Thrombocytes (Platelets)

Hematocrit = blood test for # RBC’s Polycythemia or Anemia Function • Transport oxygen (& CO 2) Shape • Biconcave discs of hemoglobin Structure • Anucleate and very few organelles Occurrence in Blood (per mm 3) • 4 -6 million (1000 RBC : 1 -WBC) Hemoglobin üIron containing protein that binds strongly to O 2 üEach hemoglobin molecule has 4 -O 2 binding sites üEach erythrocyte has 250 million hemoglobin molecules

Homeostatic Imbalance: Sickle Cell Anemia Genetic Disease Crisis: caused by a number of triggers (stress, dehydration, temp changes…) Hb (RBC) becomes deformed—sickle shaped Slows/blocks blood flow Parts of body do not receive necessary oxygen Cause extreme pain in some

Hematopoiesis: Production of Erythrocytes (Erythropoiesis) 3. Ejects nucleus and 1. Hemocytoblasts (stem cells) - cellremaining 6. bone Ejects divide many timesorganelles in red collapses. RER inward after 2 days marrow 4. Becomes a 7. Becomes a 2. Hemoglobin synthesis—HUGE reticulocyte mature RBC: AMOUNTS Erythrocyte 5. Reticulocytes enter blood stream Blood and The Cardiovascular System 14

Unable to divide, grow, or synthesize proteins Wear out in 100 to 120 days When worn out they are eliminated by phagocytes in the spleen or liver Lost cells are replaced by division of hemocytob lasts FATE OF ERYTHROCYTE

Rate of production is controlled by a protein called erythropoietin Kidneys produce more erythropoietin as a response to reduced oxygen levels in the blood Homeostasis is maintained by negative feedback from blood oxygen levels CONTROL OF ERYTHROCYTE


Types: Function üGRANULOCYTES üNeutrophils üEosinophils üBasophils • Body’s defense against disease Response • Responds to chemicals released by damaged tissues Structure üAGRANULOCYTES üLymphocytes üMonocytes • Nucleus and several organelles Movement (diapedesis) • Can move in/out of blood vessels

Types: üGRANULOCYTES üNeutrophils üEosinophils üBasophils Occurrence in Blood (per mm 3) • Normal levels are between 4, 000 -11, 000 cells per millimeter Abnormal – High - Leukocytosis üAGRANULOCYTES üLymphocytes üMonocytes • Above 11, 000 leukocytes/ml indicates an infection Abnormal – Low - Leukopenia • Commonly caused by certain drugs

Leukocytes Granulated Agranulated Neutrophils Lymphocytes Eosinophils Monocytes Basophils

Neutrophils • • • • • • • • • Multilobed nucleus (25) with fine granules More with age Act as phagocytes at active sites of infection; acute inflammatio n Most abundant; 1 st to arrive at site of infection

Eosinophils • • • • • • • • • Large, brick -red cytoplasmic granules Found in response to allergies & parasitic worms

Basophils • • • • • • • • • Initiate inflammatio n Attracts other WBC to inflamed site Have histamine containing granules Histamine is a vasodilator; Increase capillary permeabilit y for WBC’s

Lymphocytes • • • • • • • • • Nucleus fills most of the cell only WBC capable of making antibodies to identify antigens B and T cells Attack new organs in organ transplanta tion

Monocytes • • • • • • • • • Largest of the white blood cells; Kidney shaped nucleus Function as macrophag es Important in fighting chronic infection

THROMBOCYTOPENIA Platelet deficiency HEMOPHILIA Function • Needed for the clotting process Origin (megakaryocytes) • Derived from ruptured multinucleate cells Occurrence • 300, 000/mm 3 Hereditary bleeding disorder Normal clotting factors missing

HEMATOPOIESIS • 1 Blood cell formation • 2 Occurs in bone marrow • All derived from a common 3 stem cell

2 3


HEMOSTASIS Stoppage of Blood Flow Result of a Break in a Blood Vessel 3 Phases

1. VASCULAR SPASMS • Anchored platelets release serotonin, which cause blood vessel muscles to spasm - vasoconstriction • Spasms narrow blood vessel, decreasing blood loss 2. PLATELET PLUG FORMATION Collagen fibers exposed; “sticky” platelets cling to fibers --- Anchored platelets release chemicals to attract more platelets --- Platelets pile up to form a platelet plug 3. COAGULATION • Injured tissues release various blood clotting proteins to trigger a clotting cascade • Various enzymes join proteins to make a Fibrin meshwork (a clot)

Blood usually clots within 5 to 6 minutes The clot remains as endothelium regenerates The clot is broken down after tissue repair

UNDESIRABLE CLOTTING · THROMBUS · A clot in an unbroken blood vessel · Can be deadly in areas like the heart · EMBOLUS · A thrombus that breaks away and floats freely in the bloodstream · Can later clog vessels in critical areas such as the brain

HUMAN BLOOD GROUPS Blood contains genetically determined proteins; “self”antigens that are tolerated by the IS A foreign “nonself” antigen will be attacked by the immune system Blood is typed by using antibodies that will cause blood with certain “self-antigens” to clump (agglutination)

HUMAN BLOOD GROUPS There are over 30 common red blood cell antigens The most rigorous transfusion reactions are caused by the ABO and Rh blood group antigens



ABO Blood Group is based on presence/absence of 2 antigens • Type A & Type B • Lack of these is called Type O Presence of both Type A & B • Type AB Presence of either A or B • Type A or Type B, respectively


Rh Group Naming • Named after the Rhesus monkey • Presence or absence of Rh antigen America • Most Americans are Rh+ Problems • Problems occur when mixing Rh+ with Rh- blood

Rh DANGERS Only when mother is Rh- & father is Rh+ Rh- mother carrying Rh+ baby = problems • 1 st pregnancy no problems • Immune system now sensitized • 2 nd pregnancy, the mothers immune system produces antibodies to attack the Rh+ blood • Baby RBC’s swell & rupture (hemolytic disease) *anemia, jaundice, brain damage, heart failure, death*


BLOOD TYPING

Anti-Serum • Blood samples are mixed with Anti -A and Anti-B serums • IF blood clumps together when mixed with Anti-serum A, you have Type A, and vice versa • IF blood clumps with both you have Type AB • IF blood doesn’t clump at all you have Type O Coagulation/Agglutination • Whether or not it coagulates determines blood type


COMPLETE SUMMARY 39% 11% 4% 46%


A üIf you have type A blood, you can only receive types A & O blood B üIf you have type B blood, you can only receive types B & O blood AB üIf you have type AB blood, you can receive types A, B, AB, & O blood (Universal Recipient) O üIf you have type O blood, you can only receive type O blood – Most Common Blood Type! (Universal Donor)

BLOOD TRANSFUSIONS Only way to replace blood quickly Transfused blood must be of the same blood group Transfusions 15 -30% loss causes weakness Over 30% causes shock, which can be fatal

BLOOD TYPING GAME IMMUNITY GAME
- Slides: 51